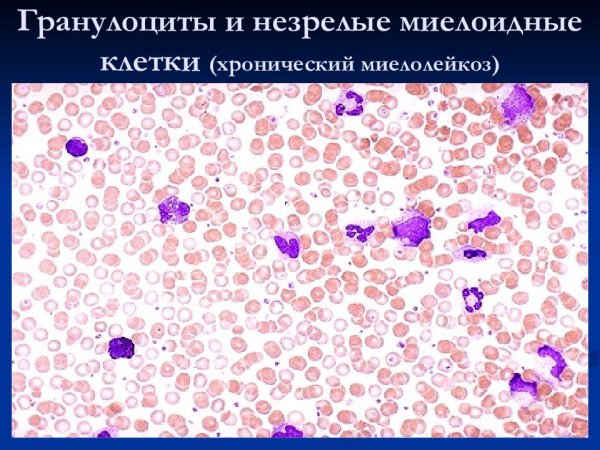
Хронический миелоидный лейкоз гистология

Плакаты Всемирного дня поддержки пациентов с хроническим миелоидным лейкозом – это яркие и значимые произведения искусства, которые призваны привлечь внимание общества к этому серьезному заболеванию. Дизайн каждого плаката разработан с особым учетом тематики и символики, связанных с хроническим миелоидным лейкозом, чтобы передать не только информацию о самой болезни, но и вызвать эмоциональный отклик у зрителей. Они могут быть использованы на различных мероприятиях, посвященных Всемирному дню поддержки пациентов с хроническим миелоидным лейкозом, и способствуют повышению осведомленности о данном заболевании, а также помогают объединить людей в борьбе против него. Эти плакаты являются не только важными информационными материалами, но и выражением солидарности с пациентами, что делает их еще более значимыми и эффективными.
Хронический миелоидный лейкоз стадии
Показатели анализа при ХМЛ
Схема кроветворения стволовые клетки
22 Сентября - Всемирный день борьбы с хроническим миелоидным лейкозом
Принципы лечения хронического миелолейкоза
Критерии ремиссии при хроническом миелолейкозе
Миелобластный лейкоз анализ крови показатели
Хронический миелолейкоз препарат
Хронический миелоидный лейкоз гистология
Хронический моноцитарный лейкоз показатели крови
ХМЛ фаза акселерации
Схема кроветворения в костном мозге
Хронический миелоцитарный лейкоз (ХМЛ)
Клинические стадии хронического миелолейкоза
ХМЛ – хронический миелобластный лейкоз
ХМЛ – хронический миелобластный лейкоз
Клетки иммунной системы т и в лимфоциты
Неблагоприятные прогностические факторы
Памятка для пациентов по профилактике лейкоза
Полипотентная стволовая кроветворная клетка
Хронический миелолейкоз формулировка диагноза
Клинические проявления хронического миелолейкоза
Дополнительные обследования при хроническом миелолейкозе
Клинико лабораторные показатели хронического миелолейкоза
Таблица исследования в терапии
Острый миелобластный лейкоз картина крови этиология патогенез
Химия терапия острый лейкоз
Лабораторные показатели при хроническом миелолейкозе
Арзамасский медицинский колледж Лукояновский филиал
Миелоцитарный лейкоз картина крови
Группы риска хронического миелолейкоза
Хронический миелолейкоз осложнения исходы
Хронический миелолейкоз патогенез
Хронический миелоцитарный лейкоз классификация
Острый лимфобластный лейкоз в2 иммунный
Миелолейкоз бластный криз
Хронический лейкоз презентация
Хронический миелолейкоз диагноз
Всемирный лень борьбы сраком
Памятка подготовка к химиотерапии
Миелобластический лейкоз
Хронический миелолейкоз формулировка диагноза
Шеина Ирина Петровна гематолог
Лабораторные показатели при хроническом миелолейкозе
Стадии хронических лейкозо
Всемирный день борьбы с хроническим миелоидным лейкозом
Всемирный день борьбы с лейкозом
Хронический миелоидный лейкоз Продолжительность жизни
Острый миелобластный лейкоз причины
Хронический миелолейкоз картина крови схема
Хронический миелоидный лейкоз
Лейкоциты схема дифференцировки

Grizly.club
Grizly.club


